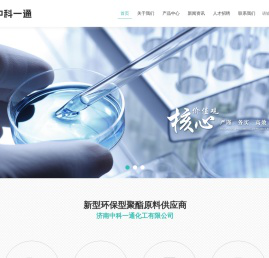
济南中科一通化工有限公司

济南中科一通化工有限公司
济南中科一通化工有限公司
SEO更新时间

百度移动:

360 权重:

搜狗权重:

关于www.jnzkyt.com说明:www.jnzkyt.com由网友主动性提交被520网址导航-自动秒收录整理收录的,520网址导航-自动秒收录仅提供www.jnzkyt.com的基础信息并免费向大众网友展示,www.jnzkyt.com的是IP地址:,www.jnzkyt.com的百度权重为、百度手机权重为、百度收录为条、360收录为条、搜狗收录为条、谷歌收录为条、百度来访流量大约在之间、百度手机端来访流量大约在之间、www.jnzkyt.com的备案号是、备案人叫、被百度收录的关键词有个、手机端关键词有个、该站点迄今为止已经创建。
内容声明:1、本站收录的内容来源于大数据收集,版权归原网站所有!
2、本站收录的内容若侵害到您的利益,请联系我们进行删除处理!
3、本站不接受违规信息,如您发现违规内容,请联系我们进行清除处理!
4、本文地址:https://www.sj520.cn/dianyingdh/52118.html,复制请保留版权链接!
您可能还喜欢
随机文章
